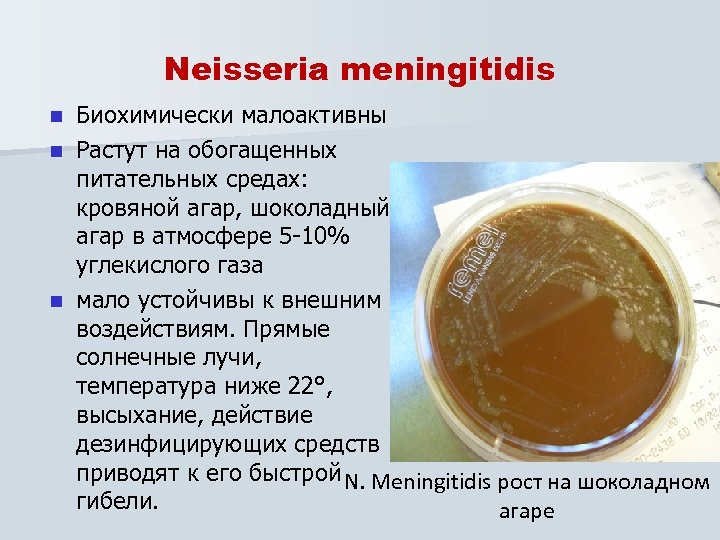
Neisseria meningitidis Биохимически малоактивны n Растут на обогащенных питательных средах: кровяной агар, шоколадный агар
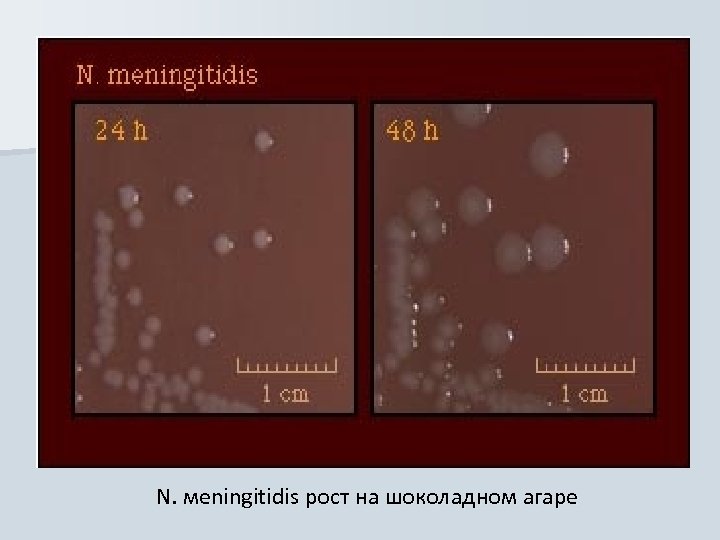
N. мeningitidis рост на шоколадном агаре

32010cbb839b4025d5c0e3b1dd1afb7a.ppt
- Количество слайдов: 27
 Семейство Neisseriaceae Род Neisseria Вид Neisseria meningitidis
Семейство Neisseriaceae Род Neisseria Вид Neisseria meningitidis
 Эпидемическая обстановка по менингококковой инфекции в последние 5 лет была в целом благополучной. n В России заболеваемость генерализованными формами менингококковой инфекции (ГФМИ) стабилизировалась на уровне до 2, 0 -2, 3 на 100 тыс. населения. n В настоящее время существует несколько зон, в которых сохранялось неблагополучие по МИ. В первую очередь, это группа дальневосточных областей, расположенных недалеко от границы с Китаем и Монголией (Хабаровский и Приморский край, Магаданская и Амурская область, Бурятия и др. ). Здесь заболеваемость в отдельные годы достигала 6 -8 случаев на 100 тыс. населения. Другим регионом со стабильно высокой заболеваемостью, от 3 до 4 на 100 тыс. , является север европейской части России - Архангельская и Мурманская области. n
Эпидемическая обстановка по менингококковой инфекции в последние 5 лет была в целом благополучной. n В России заболеваемость генерализованными формами менингококковой инфекции (ГФМИ) стабилизировалась на уровне до 2, 0 -2, 3 на 100 тыс. населения. n В настоящее время существует несколько зон, в которых сохранялось неблагополучие по МИ. В первую очередь, это группа дальневосточных областей, расположенных недалеко от границы с Китаем и Монголией (Хабаровский и Приморский край, Магаданская и Амурская область, Бурятия и др. ). Здесь заболеваемость в отдельные годы достигала 6 -8 случаев на 100 тыс. населения. Другим регионом со стабильно высокой заболеваемостью, от 3 до 4 на 100 тыс. , является север европейской части России - Архангельская и Мурманская области. n
 Заболеваемость менингококковой инфекцией в мире по-прежнему определяется, в первую очередь, эпидемиями в странах "менингитного пояса": Буркина-Фасо в 2001 -2003 гг. , Нигере в 2002 -2003 гг. , Эфиопии в 2001 -2002 гг. , Бенине в 2001 г. , Судане в 1999 г. и других. n С 2000 г. в Африке наблюдается резкий подъем заболеваемости МИ, вызванной менингококками серогруппы W 135, хотя ранее считалось, что эти менингококки ответственны только за спорадические случаи. n усложняют ситуацию вспышки МИ, вызванной менингококками серогруппы Х, в 1997 г. в Нигере и в 2000 г. в Гане (нет вакцины). n
Заболеваемость менингококковой инфекцией в мире по-прежнему определяется, в первую очередь, эпидемиями в странах "менингитного пояса": Буркина-Фасо в 2001 -2003 гг. , Нигере в 2002 -2003 гг. , Эфиопии в 2001 -2002 гг. , Бенине в 2001 г. , Судане в 1999 г. и других. n С 2000 г. в Африке наблюдается резкий подъем заболеваемости МИ, вызванной менингококками серогруппы W 135, хотя ранее считалось, что эти менингококки ответственны только за спорадические случаи. n усложняют ситуацию вспышки МИ, вызванной менингококками серогруппы Х, в 1997 г. в Нигере и в 2000 г. в Гане (нет вакцины). n
 Neisseria meningitidis n Менингококки часто присутствуют в носоглотке, не вызывая патологических явлений, но могут стать причиной развития воспалительных процессов n Это аэробные грамотрицательные диплококки, окруженные капсулой, имеют фимбрии, неподвижны
Neisseria meningitidis n Менингококки часто присутствуют в носоглотке, не вызывая патологических явлений, но могут стать причиной развития воспалительных процессов n Это аэробные грамотрицательные диплококки, окруженные капсулой, имеют фимбрии, неподвижны
Neisseria meningitidis Биохимически малоактивны n Растут на обогащенных питательных средах: кровяной агар, шоколадный агар в атмосфере 5 -10% углекислого газа n мало устойчивы к внешним воздействиям. Прямые солнечные лучи, температура ниже 22°, высыхание, действие дезинфицирующих средств приводят к его быстрой N. Meningitidis рост на шоколадном гибели. агаре n
Neisseria meningitidis Биохимически малоактивны n Растут на обогащенных питательных средах: кровяной агар, шоколадный агар в атмосфере 5 -10% углекислого газа n мало устойчивы к внешним воздействиям. Прямые солнечные лучи, температура ниже 22°, высыхание, действие дезинфицирующих средств приводят к его быстрой N. Meningitidis рост на шоколадном гибели. агаре n
N. мeningitidis рост на шоколадном агаре
N. мeningitidis рост на шоколадном агаре
 Антигены По специфичности капльных полисахаридов (капсульный антиген) выделяют 13 серогрупп n Иммунитет стойкий, группоспецифический n Наиболее часто менингококковую инфекцию вызывают представители серогрупп А, В, С, Х, Y и W-135 n
Антигены По специфичности капльных полисахаридов (капсульный антиген) выделяют 13 серогрупп n Иммунитет стойкий, группоспецифический n Наиболее часто менингококковую инфекцию вызывают представители серогрупп А, В, С, Х, Y и W-135 n
 Факторы патогенности Адгезивность –фимбрии и белки наружноймембраны n Антифагоцитарные факторы – полисахаридная капсула n Ферменты инвазии: гиалуронидаза, протеазы (инактивируют s. Ig. A – фактор местного иммунитета), нейраминидаза, фибринолизин n n Основной токсин – эндотоксин – ЛПС наружноймембраны клеточной стенки(пирогенный, провоспалительный, более высокотоксичен, чем ЛПС энтеробактерий)
Факторы патогенности Адгезивность –фимбрии и белки наружноймембраны n Антифагоцитарные факторы – полисахаридная капсула n Ферменты инвазии: гиалуронидаза, протеазы (инактивируют s. Ig. A – фактор местного иммунитета), нейраминидаза, фибринолизин n n Основной токсин – эндотоксин – ЛПС наружноймембраны клеточной стенки(пирогенный, провоспалительный, более высокотоксичен, чем ЛПС энтеробактерий)
 Иммунитет n n Капсульные полисахариды вызывают Тнезависимый иммунный ответ; даже после презентации антигенпрезентирующие клетки напрямую взаимодействуют с В-лимфоцитами Как результат, не образуются клетки памяти; основная роль в защите принадлежит антителам Образующиеся иммуноглобулины группоспецифичны Помимо циркулирующих иммуноглобулинов, большую роль в иммунном ответе играют секреторные Ig. A, система комплемента и фагоцитоз
Иммунитет n n Капсульные полисахариды вызывают Тнезависимый иммунный ответ; даже после презентации антигенпрезентирующие клетки напрямую взаимодействуют с В-лимфоцитами Как результат, не образуются клетки памяти; основная роль в защите принадлежит антителам Образующиеся иммуноглобулины группоспецифичны Помимо циркулирующих иммуноглобулинов, большую роль в иммунном ответе играют секреторные Ig. A, система комплемента и фагоцитоз
 Патогенез n n n Возбудитель обладает тропизмом к слизистой оболочке носоглотки, на которой при определенных условиях размножается и выделяется с носоглоточной слизью во внешнюю среду, что соответствует наиболее частой форме инфекции - менингококконосительству. При снижении активности местного иммунитета, нарушении микробиоценоза менингококк может внедриться вглубь слизистой оболочки, вызывая воспаление и симптомы назофарингита. Лишь у 5% больных назофарингитом менингококк, преодолевая местные барьеры, проникаете сосуды подслизистого слоя, а затем распространяется гематогенным путем. Гематогенная диссеминация возбудителя обусловливает развитие генерализованных форм инфекции. В крови менингококки активно размножаются. При гибели бактерий высвобождается эндотоксин, сходный по биохимическим и биологическим свойствам с эндотоксином кишечных бактерий: вызывает гипотензию и сосудистый коллапс, повреждение эндотелия сосудов, в результате чего образуются кровоизлияния во внутренних органах, сыпь; вызывает диссеминированное внутрисосудистое свертывание крови, тромбозы
Патогенез n n n Возбудитель обладает тропизмом к слизистой оболочке носоглотки, на которой при определенных условиях размножается и выделяется с носоглоточной слизью во внешнюю среду, что соответствует наиболее частой форме инфекции - менингококконосительству. При снижении активности местного иммунитета, нарушении микробиоценоза менингококк может внедриться вглубь слизистой оболочки, вызывая воспаление и симптомы назофарингита. Лишь у 5% больных назофарингитом менингококк, преодолевая местные барьеры, проникаете сосуды подслизистого слоя, а затем распространяется гематогенным путем. Гематогенная диссеминация возбудителя обусловливает развитие генерализованных форм инфекции. В крови менингококки активно размножаются. При гибели бактерий высвобождается эндотоксин, сходный по биохимическим и биологическим свойствам с эндотоксином кишечных бактерий: вызывает гипотензию и сосудистый коллапс, повреждение эндотелия сосудов, в результате чего образуются кровоизлияния во внутренних органах, сыпь; вызывает диссеминированное внутрисосудистое свертывание крови, тромбозы
 Бактериемия N. meningitidis в нейтрофилах (окраска метиленовым синим)
Бактериемия N. meningitidis в нейтрофилах (окраска метиленовым синим)

 Клинические проявления n Локализованные v Субклиническая формы: форма инфекции носоглотки v Менингококковый назофарингит – местный воспалительный процесс с умеренными клиническими проявлениями
Клинические проявления n Локализованные v Субклиническая формы: форма инфекции носоглотки v Менингококковый назофарингит – местный воспалительный процесс с умеренными клиническими проявлениями
 Клинические проявления n Генерализованные формы: Менингококкемия v Молниеносная менингококкемия – менингококкемия с явлениями сосудодвигательного коллапса и шока, часто заканчивается летально за несколько часов v Хроническая менингококкемия v Менингит - Проникая через гемато-энцефалический барьер менингококки внедряются в субарахноидальное пространство, вызывая серозно-гнойное (или гнойное) воспаление мягких оболочек мозга – менингит v
Клинические проявления n Генерализованные формы: Менингококкемия v Молниеносная менингококкемия – менингококкемия с явлениями сосудодвигательного коллапса и шока, часто заканчивается летально за несколько часов v Хроническая менингококкемия v Менингит - Проникая через гемато-энцефалический барьер менингококки внедряются в субарахноидальное пространство, вызывая серозно-гнойное (или гнойное) воспаление мягких оболочек мозга – менингит v
 Клинические проявления n Генерализованные (продолжение) формы: v Менингоэнцефалит – сочетанное воспаление оболочек и вещества головного мозга v Смешанная форма (менингококкемия плюс менингит)
Клинические проявления n Генерализованные (продолжение) формы: v Менингоэнцефалит – сочетанное воспаление оболочек и вещества головного мозга v Смешанная форма (менингококкемия плюс менингит)
 Менингококковый сепсис Сыпь при менингите
Менингококковый сепсис Сыпь при менингите
 Эпидемиология n n n Источник инфекции в очагах распространения – бактерионосители Наиболее высока заболеваемость среди детей от 6 мес. до 1 года Развитие болезни зависит главным образом от иммунологического статуса и вирулентности штамма Менингококковый менингит встречается в основном у детей в возрасте 6 мес. – 10 лет Существует корреляция между восприимчивостью к мкнингококковому заболеванию и отсутствием антител У большинства взрослых антитела к менингококкам обнаруживаются, что можетбытьследствием естесственной иммунизации при бессимптомном носительстве
Эпидемиология n n n Источник инфекции в очагах распространения – бактерионосители Наиболее высока заболеваемость среди детей от 6 мес. до 1 года Развитие болезни зависит главным образом от иммунологического статуса и вирулентности штамма Менингококковый менингит встречается в основном у детей в возрасте 6 мес. – 10 лет Существует корреляция между восприимчивостью к мкнингококковому заболеванию и отсутствием антител У большинства взрослых антитела к менингококкам обнаруживаются, что можетбытьследствием естесственной иммунизации при бессимптомном носительстве
 Микробиологическая диагностика менингококковой инфекции Материал для исследования n Клинический материал - ликвор, кровь, слизь из носоглотки. При спинномозговой пункции ликвор вытекает струей и обычно мутный. Пробы хранят не более 2 -3 час до исследования Взятие мазка (nasopharynx)
Микробиологическая диагностика менингококковой инфекции Материал для исследования n Клинический материал - ликвор, кровь, слизь из носоглотки. При спинномозговой пункции ликвор вытекает струей и обычно мутный. Пробы хранят не более 2 -3 час до исследования Взятие мазка (nasopharynx)
 Экспресс - методы n Иммунофлуоресцентный прямой n Бактериоскопический (микроскопия мазка из мутного ликвора, вытекающего под давлением по Граму)
Экспресс - методы n Иммунофлуоресцентный прямой n Бактериоскопический (микроскопия мазка из мутного ликвора, вытекающего под давлением по Граму)
 1. Бактериологический метод Цель бактериологического метода диагностики – выделение и идентификация возбудителя из слизи носоглотки, ликвора, крови (при необходимости пробы центрифугируют) 1 -этап – посев исследуемого материала на плотные питательные среды для получения изолированных колоний - кровяной агар, сывороточные среды, асцит агар. Инкубируют при 37°С, 24 -48 час. , в атмосфере содержащей 10% углекислого газа.
1. Бактериологический метод Цель бактериологического метода диагностики – выделение и идентификация возбудителя из слизи носоглотки, ликвора, крови (при необходимости пробы центрифугируют) 1 -этап – посев исследуемого материала на плотные питательные среды для получения изолированных колоний - кровяной агар, сывороточные среды, асцит агар. Инкубируют при 37°С, 24 -48 час. , в атмосфере содержащей 10% углекислого газа.
 1. Бактериологический метод (продолжение) n n n 2 -этапизучение выросших колоний (макроскопическое и микроскопическое) и пересев на скошенный сывороточный агар для получения чистой культуры После суточной инкубации образуются голубоватые колонии с ровными краями и гладкой поверхностью 3 -этап-идентификация возбудителя Биохимическое типирование Менингококки ферментируют только мальтозу, глюкозу Тест на чувствительность к антибиотикам
1. Бактериологический метод (продолжение) n n n 2 -этапизучение выросших колоний (макроскопическое и микроскопическое) и пересев на скошенный сывороточный агар для получения чистой культуры После суточной инкубации образуются голубоватые колонии с ровными краями и гладкой поверхностью 3 -этап-идентификация возбудителя Биохимическое типирование Менингококки ферментируют только мальтозу, глюкозу Тест на чувствительность к антибиотикам


 Серологический метод диагностики n антигены возбудителя выявляют с помощью иммунных сывороток или выявляют антитела в сыворотке пациента, применяя реакцию иммунофлюоресценции (ИФ), иммуноферментный анализ (ИФА) n Встречный иммуноэлектрофорез и иммунодиффузию в агаре используют для выявления менингококковых антигенов в ликворе
Серологический метод диагностики n антигены возбудителя выявляют с помощью иммунных сывороток или выявляют антитела в сыворотке пациента, применяя реакцию иммунофлюоресценции (ИФ), иммуноферментный анализ (ИФА) n Встречный иммуноэлектрофорез и иммунодиффузию в агаре используют для выявления менингококковых антигенов в ликворе
 Лечение n Антибиотикотерапия: препарат выбора – пенициллин G, ампициллин и цефалоспорины 3 поколения
Лечение n Антибиотикотерапия: препарат выбора – пенициллин G, ампициллин и цефалоспорины 3 поколения
 Специфическая профилактика Инактивированная химическая менингококковая вакцина – содержит капсульные полисахариды n В настоящее время выпускаются моно (A), ди (A+C) и поливалентные менингококковые вакцины, обладающие высокой протективной активностью и малой реактогенностью. В РФ выпускается моно-Авакцина, а также зарегистрированы А и С-вакцины (НИИЭМ им. Г. Н. Габричевского, Россия и фирмы "Пастер Мерье Коннот", Франция). Вакцина, выпускаемая в США, содержит антигены 4 серогрупп: A, C, Y и W-135. n
Специфическая профилактика Инактивированная химическая менингококковая вакцина – содержит капсульные полисахариды n В настоящее время выпускаются моно (A), ди (A+C) и поливалентные менингококковые вакцины, обладающие высокой протективной активностью и малой реактогенностью. В РФ выпускается моно-Авакцина, а также зарегистрированы А и С-вакцины (НИИЭМ им. Г. Н. Габричевского, Россия и фирмы "Пастер Мерье Коннот", Франция). Вакцина, выпускаемая в США, содержит антигены 4 серогрупп: A, C, Y и W-135. n


